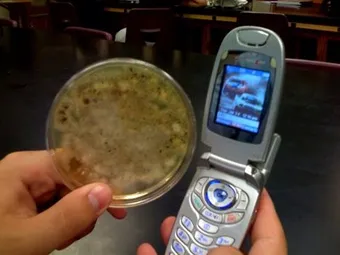

Мобильные телефоны оказались в 18 раз грязнее рукояток бачков в общественных туалетах
Исследование, предпринятое британским журналом Which?, показало, что на поверхности мобильных телефонов обитает в 18 раз больше бактерий, чем на рукоятках бачков общественных туалетов, сообщает Daily Mail.
Эксперт Кери Стэнэуэй (Ceri Stanaway) определил общее микробное число в мазках с 30 случайно подобранных мобильных телефонов и сравнил его с аналогичным показателем, полученным при исследовании туалетных рукояток.
Выяснилось, что число микроорганизмов на поверхности телефонов в 25 раз превышает гигиеническую норму и в 18 раз – число микробов на рукоятках смыва в общественных уборных.
Речь идет об общем количестве бактерий. Не все из них патогенны для человека, однако были обнаружены и болезнетворные микробы, например, возбудители кишечных и гнойных инфекций – сальмонелла, кишечная палочка и золотистый стафилококк.
По оценкам исследователя, примерно14,7 миллионов из 63 миллионов мобильных телефонов, используемых британцами, представляют угрозу для здоровья.
На основании полученных результатов Стэнэуэй порекомендовал всем пользователям мобильников уделять самое пристальное внимание гигиене своих устройств и стараться не давать их в чужие руки, например, при просмотре фотографий.